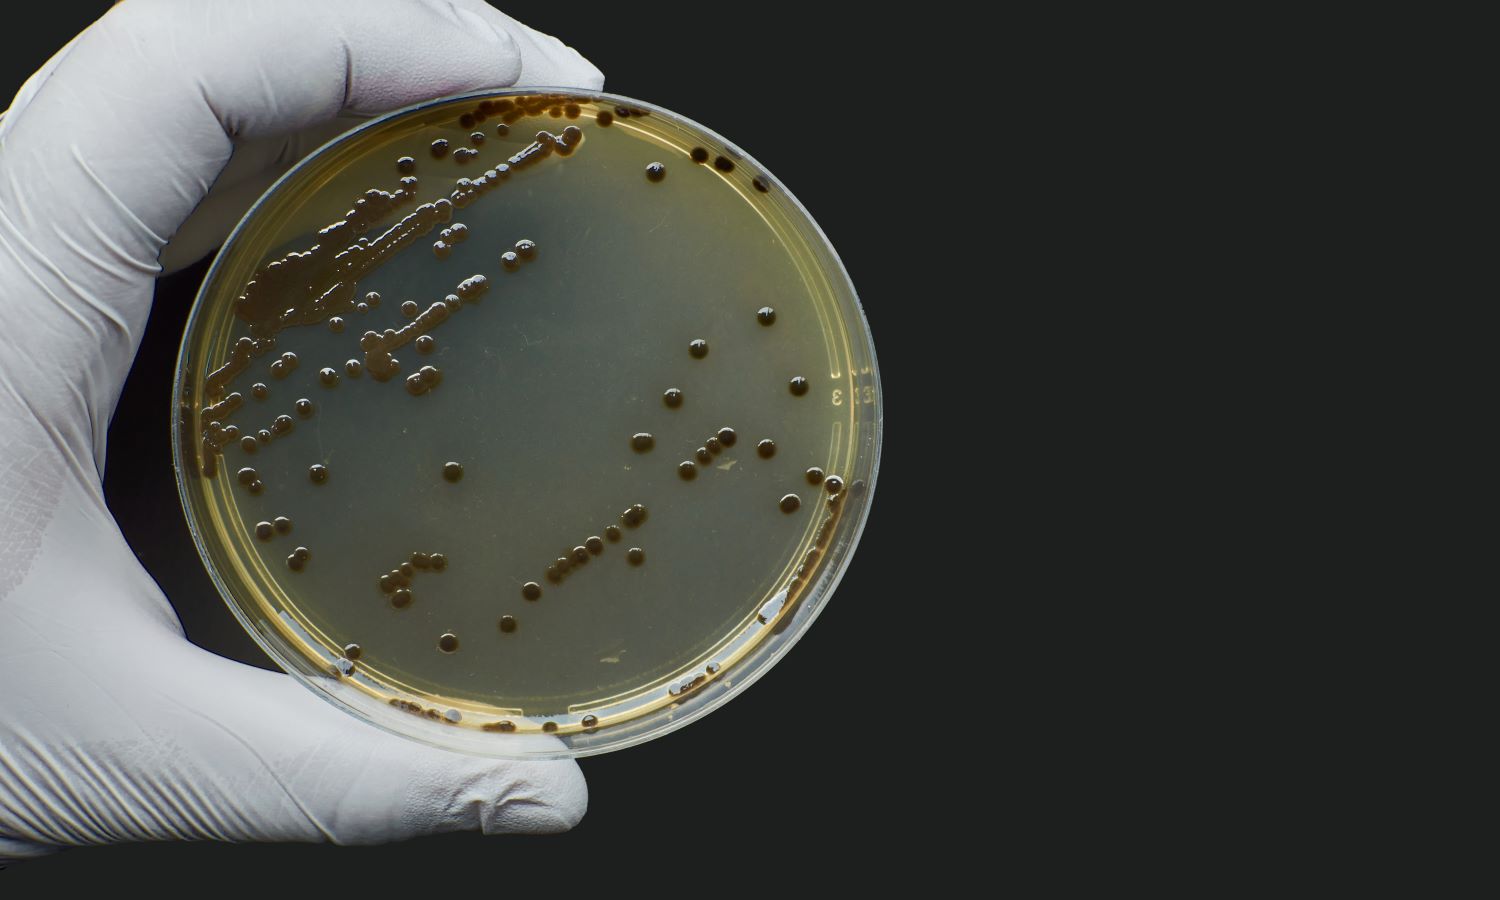
Clostridium perfringens

At ECT Water Microbiology, we provide reliable Clostridium perfringens water testing services to detect potential faecal contamination and ensure the safety and purity of your water supply.
What Is Clostridium perfringens?
Clostridium perfringens is a spore-forming bacteria which, when present in water, indicates possible faecal pollution. While Clostridium perfringens in water do not multiply, its spores are highly resistant to harsh conditions (e.g., disinfection chemicals and UV treatment).
As Clostridium perfringens can persist in water supplies for extended periods, it is a reliable indicator of historical faecal contamination. This is different to Faecal Coliforms (including E. coli) and Faecal Streptococci, which do not survive long outside of the body and only indicate recent faecal pollution.
The presence of Clostridium perfringens in water may also suggest the presence of enteric viruses and protozoa coming from intermittent sources of contamination of surface water.

Our Clostridium perfringens in Water Testing Services
Clostridium perfringens is commonly found in soil, faeces, and the intestines of humans and animals. It is one of the most common causes of food poisoning (as well as causing fasciitis, cellulitis, and gas gangrene). However, it can sometimes be ingested and cause no harm.
At ECT Water Microbiology, we can test for Clostridium perfringens in water samples such as potable, raw, and bottled water, sewage, swimming pool water, bowser water, and more – helping you ensure your water supply / system is safe for humans and the environment.
We are committed to combining quality of service with value, offering competitive and transparent pricing, with no hidden add-ons. Working on a case-by-case basis, we will review your actual needs so there is no unnecessary testing.
Why Choose ECT Water Microbiology for Clostridium perfringens in Water Testing?
- 24 drop-off locations across the UK & Ireland
- Purpose-built, high-capacity laboratory
- Highly experienced team
- Secure & compliant sample handling
- Efficient analysis
- Reliable, accurate results
- 24/7 access to reports with the LabTrac app & CTS Portal













